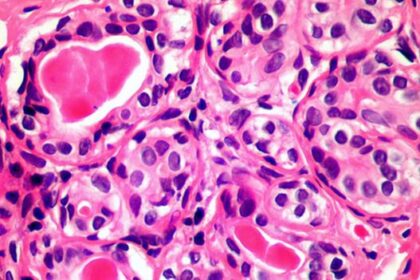
cancer

QNB participe à la campagne de sensibilisation à l’importance du dépistage précoce du cancer du sein
La QNB participe à la campagne de sensibilisation à l'importance du dépistage…
3500 cas de cancer du sein recensés chaque année en Tunisie
Le ministre donnait le coup d'envoi, samedi à El Fahs (Gouvernorat de…
ATEL – CNTS : Lancement d’une campagne de don de sang et de plaquettes
L’Association Tunisienne des Enfants Leucémiques (ATEL) a annoncé, aujourd’hui 20 février 2021, la…
Le Japon accorde un don à l’Association Tunisienne d’Assistance aux Malades du Cancer du Sein
Ce don, d’un montant de 244.839DT, a été accordé mercredi à l'Association…
Un traitement universel du cancer pour bientôt ?
Des scientifiques gallois découvrent une nouvelle technique d’immunothérapie anticancéreuse pour un grand…
QNB Tunisie célèbre le mois de la mobilisation contre le cancer du sein
QNB Tunisie a participé à la campagne de sensibilisation au Cancer du…
Cancer : entre 11 et 12 mille nouveaux cas par an en Tunisie
Entre 11 et 12 mille nouveaux cas de cancer sont enregistrés par…
Marathon Nourane : La FONDATION BNA en rose
La Fondation BNA s’engage et apportera le 20 ocotbre son soutien à…
Le Prix Nobel de Médecine décerné à deux Américains et un Britannique
Le prix Nobel de médecine est décerné, cette année, à deux Américains…
Les bienfaits du jeûne dans la lutte contre le vieillissement et le cancer!
Des études scientifiques dévoilent les vertus inattendues du jeûne contre le cancer,…